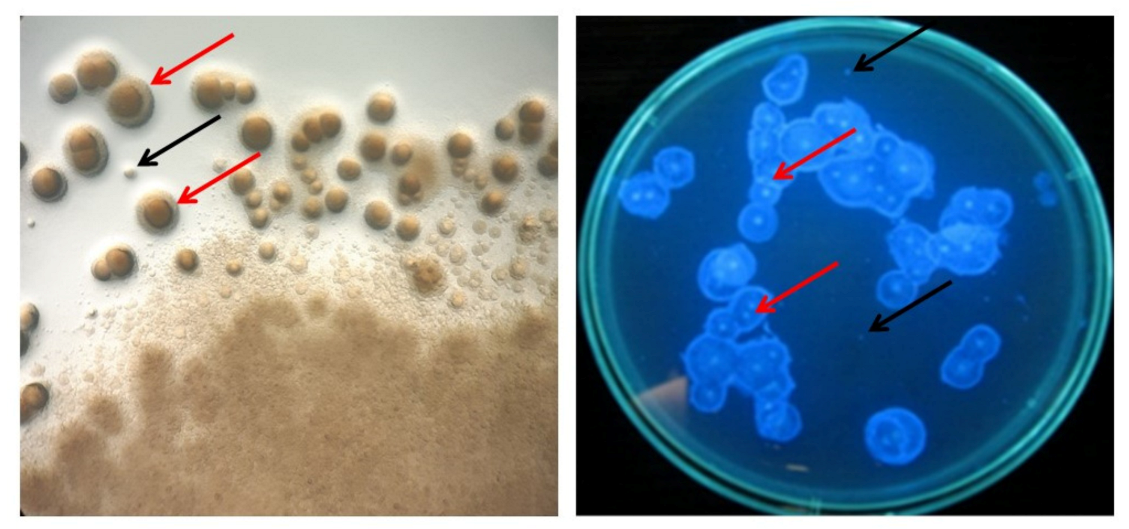
Polymers 13 03950 g005

Preparation of Komagataeibacter xylinus Inoculum for Bacterial Cellulose Biosynthesis Using Magnetically Assisted External-Loop Airlift Bioreactor
Abstract
:1. Introduction
2. Materials and Methods
2.1. Experimental Apparatus
2.2. Inoculum Preparation in RMF-Assisted EL-ALB
2.3. Assessment of Fermentation Parameters
2.4. Evaluation of Inoculum Quality Produced in the RMF-Assisted EL-ALB
2.4.1. Determination of the Number of Living Cells
2.4.2. Determination of the Cells’ Metabolic Activity
2.4.3. Determination of Cellulose-Deficient (Cel−) Mutants
2.4.4. Assessment of the Cells’ Ability to Produce BC
2.5. Evaluation of the Classical Methods of Inoculum Preparation
2.6. Analysis of Physicochemical Properties of BC Depending on the Age of the Inoculum Produced in RMF-Assisted EL-ALB
2.6.1. Evaluation of Mechanical Properties
2.6.2. Scanning Electron Microscopy Analysis
2.6.3. ATR-FTIR Analysis of BC
2.6.4. Determination of Water Swelling Ratio
2.6.5. Determination of Water Holding Capacity
2.7. Statistical Analysis
3. Results and Discussion
3.1. Measurements of Cellular Parameters
3.2. Fermentation Parameters-pH and DO%
3.3. Determination of Cellulose-Deficient (Cel−) Mutants
3.4. Assessment of Cell Ability to Produce BC
3.5. Analysis of Physicochemical Properties of BC
4. Conclusions
Supplementary Materials
Author Contributions
Funding
Institutional Review Board Statement
Informed Consent Statement
Data Availability Statement
Conflicts of Interest
References
- Azeredo, H.; Barud, H.; Farinas, C.S.; Vasconcellos, V.M.; Claro, A. Bacterial cellulose as a raw material for food and food packaging applications. Front. Sustain. Food Syst. 2019, 3, 7. [Google Scholar] [CrossRef] [Green Version]
- Gorgieva, S.; Trcek, J. Bacterial Cellulose: Production, modification and perspectives in biomedical applications. Nanomaterials 2019, 9, 1352. [Google Scholar] [CrossRef] [PubMed] [Green Version]
- Ullah, H.; Santos, H.A.; Khan, T. Applications of bacterial cellulose in food, cosmetics and drug delivery. Cellulose 2016, 23, 2291–2314. [Google Scholar] [CrossRef]
- Wang, J.; Tavakoli, J.; Tang, T. Bacterial cellulose production, properties and applications with different culture methods—A review. Carbohydr. Polym. 2019, 219, 63–76. [Google Scholar] [CrossRef] [Green Version]
- Chao, Y.; Sugano, Y.; Shoda, M. Bacterial cellulose production under oxygen-enriched air at different fructose concentrations in a 50-L, internal-loop airlift reactor. Appl. Microbiol. Biotechnol. 2001, 55, 673–679. [Google Scholar] [CrossRef]
- Lin, S.P.; Hsieh, S.C.; Chen, K.I.; Demirci, A.; Cheng, K.C. Semi-continuous bacterial cellulose production in a rotating disk bioreactor and its materials properties analysis. Cellulose 2014, 21, 835–844. [Google Scholar] [CrossRef]
- Sood, S.; Singhal, R.; Bhat, S.; Kumar, A. Comprehensive Biotechnology; Murray, M.-Y., Ed.; Pergamon: Oxford, UK, 2011; pp. 230–243. [Google Scholar]
- Nguyen, D.N.; Ton, N.M.N.; Le, V.V.M. Optimization of Saccharomyces cerevisiae immobilization in bacterial cellulose by ‘adsorption-incubation’ method. Int. Food Res. J. 2009, 16, 59–64. [Google Scholar]
- Stanbury, P.F.; Whitaker, A.; Hall, S.J. Principles of Fermentation Technology, 3rd ed.; Butterworth-Heinemann: Oxford, UK, 2017; pp. 335–399. [Google Scholar]
- Żywicka, A.; Junka, A.; Ciecholewska-Juśko, D.; Migdał, P.; Czajkowska, J.; Fijałkowski, K. Significant enhancement of citric acid production by Yarrowia lipolytica immobilized in bacterial cellulose-based carrier. J. Biotechnol. 2020, 321, 13–22. [Google Scholar] [CrossRef]
- Webb, C.; Kamat, S.P. Improving fermentation consistency through better inoculum preparation. World J. Microbiol. Biotechnol. 1993, 9, 308–312. [Google Scholar] [CrossRef]
- Blasco, L.; Kahala, M.; Tampio, E.; Vainio, M.; Ervasti, S.; Rasi, S. Effect of inoculum pretreatment on the composition of microbial communities in anaerobic digesters producing volatile fatty acids. Microorganisms 2020, 8, 581–613. [Google Scholar] [CrossRef] [Green Version]
- Rajput, A.A.; Sheikh, Z. Effect of inoculum type and organic loading on biogas production of sunflower meal and wheat straw. Sustain. Environ. Res. 2019, 29, 4. [Google Scholar] [CrossRef] [Green Version]
- Wang, Z.G.; Xiang, D.; Wang, X.B.; Li, C.F. Preparation of an inoculum of Gluconacetobacter xylinus without mutants in shaken culture. J. Appl. Microbiol. 2016, 121, 713–720. [Google Scholar] [CrossRef] [PubMed]
- Atwa, N.A.; El-Diwany, A.I.; El-Saied, H.; Basta, A.H. Improvement in bacterial cellulose production using Gluconacetobacter xylinus ATCC 10245 and characterization of the cellulose pellicles produced. Egypt. Pharm. J. 2015, 14, 123–129. [Google Scholar] [CrossRef]
- Hornung, M.; Ludwig, M.; Gerrard, A.M.; Schmauder, H.P. Optimizing the production of bacterial cellulose in surface culture: Evaluation of substrate mass transfer influences on the bioreaction. Eng. Life Sci. 2006, 6, 537–545. [Google Scholar] [CrossRef]
- Lin, S.P.; Huang, Y.H.; Hsu, K.D.; Lai, Y.J.; Chen, Y.K.; Cheng, K.C. Isolation and identification of cellulose-producing strain Komagataeibacter intermedius from fermented fruit juice. Carbohydr. Polym. 2016, 151, 827–833. [Google Scholar] [CrossRef]
- Żywicka, A.; Junka, A.; Szymczyk, P.; Chodaczek, G.; Grzesiak, J.; Sedghizadeh, P.; Fijałkowski, K. Bacterial cellulose yield increased over 500% by supplementation of medium with vegetable oil. Carbohydr. Polym. 2018, 199, 294–303. [Google Scholar] [CrossRef]
- Ha, J.H.; Shah, N.; Ul-Islam, M.; Khan, T.; Park, J.K. Bacterial cellulose production from a single sugar alpha-linked glucuronic acid-based oligosaccharide. Process Biochem. 2011, 46, 1717–1723. [Google Scholar] [CrossRef]
- Kthiri, A.; Hidouri, S.; Wiem, T.; Jeridi, R.; Sheehan, D.; Landouls, A. Biochemical and biomolecular effects induced by a static magnetic field in Saccharomyces cerevisiae: Evidence for oxidative stress. PLoS ONE 2019, 14, e0209843. [Google Scholar] [CrossRef] [Green Version]
- Muniz, J.B.; Marcelino, M.; da Motta, M.; Schuler, A.; da Motta, M.A. Influence of static magnetic fields on S. cerevisae biomass growth. Braz. Arch. Biol. Technol. 2007, 50, 515–520. [Google Scholar] [CrossRef] [Green Version]
- Tomska, A.; Wolny, L. Enhancement of biological wastewater treatment by magnetic field exposure. Bioresour. Technol. 2010, 101, 8535–8540. [Google Scholar] [CrossRef]
- Drozd, R.; Rakoczy, R.; Wasak, A.; Junka, A.; Fijałkowski, K. The application of magnetically modified bacterial cellulose for immobilization of laccase. Int. J. Biol. Macromol. 2018, 108, 462–470. [Google Scholar] [CrossRef] [PubMed]
- Drozd, R.; Szymańska, M.; Żywicka, A.; Kowalska, U.; Rakoczy, R.; Kordas, M.; Konopacki, M.; Junka, A.F.; Fijałkowski, K. Exposure to non-continuous rotating magnetic field induces metabolic strain-specific response of Komagataeibacter xylinus. Biochem. Eng. J. 2021, 166, 107855. [Google Scholar] [CrossRef]
- Fijałkowski, K.; Żywicka, A.; Drozd, R.; Niemczyk, A.; Junka, A.F.; Peitler, D.; Kordas, M.; Konopacki, M.; Szymczyk, P.; El Fray, M.; et al. Modification of bacterial cellulose through exposure to the rotating magnetic field. Carbohydr. Polym. 2015, 133, 52–60. [Google Scholar] [CrossRef] [PubMed]
- Fijałkowski, K.; Rakoczy, R.; Żywicka, A.; Drozd, R.; Zielińska, B.; Wenelska, K.; Cendrowski, K.; Peitler, D.; Kordas, M.; Konopacki, M.; et al. Time dependent influence of rotating magnetic field on bacterial cellulose. Int. J. Polym. Sci. 2016, 2016, 7536397. [Google Scholar] [CrossRef] [Green Version]
- Fijałkowski, K.; Żywicka, A.; Drozd, R.; Junka, A.F.; Peitler, D.; Kordas, M.; Konopacki, M.; Szymczyk, P.; Rakoczy, R. Increased water content in bacterial cellulose synthesized under rotating magnetic fields. Electromagn. Biol. Med. 2017, 36, 192–201. [Google Scholar] [CrossRef]
- Fijałkowski, K.; Nawrotek, P.; Struk, M.; Kordas, M.; Rakoczy, R. The effects of rotating magnetic field on growth rate, cell metabolic activity and biofilm formation by Staphylococcus aureus and Escherichia coli. J. Magn. 2013, 18, 289–296. [Google Scholar] [CrossRef] [Green Version]
- Fijałkowski, K.; Nawrotek, P.; Struk, M.; Kordas, M.; Rakoczy, R. Effects of rotating magnetic field exposure on the functional parameters of different species of bacteria. Electromagn. Biol. Med. 2015, 34, 48–55. [Google Scholar] [CrossRef]
- Fijałkowski, K.; Drozd, R.; Żywicka, A.; Junka, A.F.; Kordas, M.; Rakoczy, R. Biochemical and cellular properties of Gluconacetobacter xylinus cultures exposed to different modes of rotating magnetic field. Pol. J. Chem. Technol. 2017, 19, 107–114. [Google Scholar] [CrossRef] [Green Version]
- Konopacka, A.; Rakoczy, R.; Konopacki, M. The effect of rotating magnetic field on bioethanol production by yeast strain modified by ferrimagnetic nanoparticles. J. Magn. Magn. Mater. 2018, 473, 176–183. [Google Scholar] [CrossRef]
- Lechowska, J.; Kordas, M.; Konopacki, M.; Fijałkowski, K.; Drozd, R.; Rakoczy, R. Hydrodynamic studies in magnetically assisted external-loop airlift reactor. Chem. Eng. J. 2019, 362, 298–309. [Google Scholar] [CrossRef]
- Rampersad, S.N. Multiple applications of Alamar Blue as an indicator of metabolic function and cellular health in cell viability bioassays. Sensors 2012, 12, 12347–12360. [Google Scholar] [CrossRef]
- Drozd, R.; Rakoczy, R.; Konopacki, M.; Frąckowiak, A.; Fijałkowski, K. Evaluation of usefulness of 2DCorr technique in assessing physicochemical properties of bacterial cellulose. Carbohydr. Polym. 2017, 161, 208–218. [Google Scholar] [CrossRef]
- Nelson, M.L.; O’Connor, R.T. Relation of certain infrared bands to cellulose crystallinity and crystal latticed type. Part I. Spectra of lattice types I, II, III and of amorphous cellulose. J. Appl. Polym. Sci. 1964, 8, 1311–1324. [Google Scholar] [CrossRef]
- Ha, S.-J.; Kim, S.-Y.; Seo, J.-H.; Oh, D.-K.; Lee, J.-K. Optimization of culture conditions and scale-up to pilot and plant scales for coenzyme Q10 production by Agrobacterium tumefaciens. Appl. Microbiol. Biotechnol. 2007, 74, 974–980. [Google Scholar] [CrossRef]
- Jung, H.-M.; Kim, S.-Y.; Moon, H.-J.; Oh, D.-K.; Lee, J.-K. Optimization of culture conditions and scale-up to pilot and plant scales for vancomycin production by Amycolatopsis orientalis. Appl. Microbiol. Biotechnol. 2007, 77, 789–795. [Google Scholar] [CrossRef]
- Ruka, D.R.; Simon, G.P.; Dean, K.M. Altering the growth conditions of Gluconacetobacter xylinus to maximize the yield of bacterial cellulose. Carbohydr. Polym. 2012, 89, 613–622. [Google Scholar] [CrossRef]
- Wu, S.-C.; Li, M.H. Production of bacterial cellulose membranes in a modified airlift bioreactor by Gluconacetobacter xylinus. J. Biosci. Bioeng. 2015, 120, 444–449. [Google Scholar] [CrossRef]
- Reiniati, I.; Hrymak, A.H.; Margaritis, A. Kinetics of cell growth and crystalline nanocellulose production by Komagataeibacter xylinus. Biochem. Eng. J. 2017, 127, 21–31. [Google Scholar] [CrossRef]
- Cheng, H.-P.; Wang, P.-M.; Chen, J.-W.; Wu, W.-T. Cultivation of Acetobacter xylinum for bacterial cellulose production in a modified airlift reactor. Appl. Biochem. Biotechnol. 2002, 35, 125–132. [Google Scholar] [CrossRef]
- Kongruang, S. Bacterial BC production by Acetobacter xylinum strains from agricultural waste products. Appl. Biochem. Biotechnol. 2008, 148, 245–256. [Google Scholar] [CrossRef]
- Augimeri, R.V.; Varley, A.J.; Strap, J.L. Establishing a role for bacterial cellulose in environmental interactions: Lessons learned from diverse biofilm-producing Proteobacteria. Front. Microbiol. 2015, 6, 1282. [Google Scholar] [CrossRef] [PubMed] [Green Version]
- Park, K.J.; Jung, J.Y.; Park, Y.H. Cellulose production by Gluconacetobacter hansenii in a medium containing ethanol. Biotechnol. Lett. 2003, 25, 2055–2059. [Google Scholar] [CrossRef] [PubMed]
- Aydin, Y.A.; Aksoy, N.D. Isolation and characterization of an efficient bacterial cellulose producer strain in agitated culture: Gluconacetobacter hansenii P2A. Appl. Microbiol. Biotechnol. 2014, 98, 10651075. [Google Scholar] [CrossRef] [PubMed]
- Chawla, P.; Bajaj, I.; Shrikant, S.; Singhal, R.S. Microbial Cellulose: Fermentative Production and Applications. Food Technol. Biotechnol. 2009, 47, 107–124. [Google Scholar]
- Song, H.J.; Li, H.; Seo, J.H.; Kim, M.-J.; Kim, S.-J. Pilot-scale production of bacterial cellulose by a spherical type bubble column bioreactor using saccharified food wastes. Korean J. Chem. Eng. 2009, 26, 141–146. [Google Scholar] [CrossRef]
- Aswini, K.; Gopal, N.O.; Uthandi, S. Optimized culture conditions for bacterial cellulose production by Acetobacter senegalensis MA1. BMC Biotechnol. 2020, 20, 46. [Google Scholar] [CrossRef]
- Cheng, Z.; Yang, R.; Liu, X.; Chen, H. Green synthesis of bacterial cellulose via acetic acid pre-hydrolysis liquor of agricultural corn stalk used as carbon source. Bioresour. Technol. 2017, 234, 8–14. [Google Scholar] [CrossRef]
- Yanti, N.A.; Ahmad, S.W.; Muhiddin, N.H. Evaluation of inoculum size and fermentation period for bacterial cellulose production from sago liquid waste. J. Phys. 2018, 11, 52076. [Google Scholar] [CrossRef]
- Potivara, K.; Phisalaphong, M. Development and characterization of bacterial cellulose reinforced with natural rubber. Materials 2019, 12, 2323. [Google Scholar] [CrossRef] [Green Version]
- Treesuppharat, W.; Rojanapanthu, P.; Siangsanoh, C.; Manuspiya, H.; Ummartyotin, S. Synthesis and characterization of bacterial cellulose and gelatin-based hydrogel composites for drug-delivery systems. Biotechnol. Rep. (Amst.) 2017, 6, 84–91. [Google Scholar] [CrossRef]
- Ul Islam, M.; Khan, T.; Kon Park, J.K. Water holding and release properties of bacterial cellulose obtained by in situ and ex situ modification. Carbohydr. Polym. 2012, 88, 596–603. [Google Scholar] [CrossRef]
- Tsouko, E.; Kourmentza, C.; Ladakis, D.; Kopsahelis, N.; Mandala, I.; Papanikolaou, S.; Paloukis, F.; Alves, V.; Koutinas, A. Bacterial cellulose production from industrial waste and by-product streams. Int. J. Mol. Sci. 2015, 16, 14832–14849. [Google Scholar] [CrossRef]
- Ciecholewska-Juśko, D.; Broda, M.; Żywicka, A.; Styburski, D.; Sobolewski, P.; Gorący, K.; Migdał, P.; Junka, A.; Fijałkowski, K. Potato juice, a starch industry waste, as a cost-effective medium for the biosynthesis of bacterial cellulose. Int. J. Mol. Sci. 2021, 22, 10807. [Google Scholar] [CrossRef]
- Tokoh, C.; Takabe, K.; Fujita, M.; Saiki, H. Cellulose synthesized by Acetobacter xylinum in the presence of acetyl glucomannan. Cellulose 1998, 5, 249–261. [Google Scholar] [CrossRef]
- Kaminski, K.; Jarosz, M.; Grudzien, J.; Pawlik, J.; Zastawnik, F.; Pandyra, P.; Kołodziejczyk, M.A. Hydrogel bacterial cellulose: A path to improved materials for new eco-friendly textiles. Cellulose 2020, 27, 5353–5365. [Google Scholar] [CrossRef] [Green Version]
- Stanisławska, A.; Staroszczyk, H.; Szkodo, M. The effect of dehydration/rehydration of bacterial nanocellulose on its tensile strength and physicochemical properties. Carbohydr. Polym. 2020, 236, 116023. [Google Scholar] [CrossRef]
- Chen, S.Q.; Lopez-Sanchez, P.; Wang, D.; Mikkelsen, D.; Gidley, M.J. Mechanical properties of bacterial cellulose synthesised by diverse strains of the genus Komagataeibacter. Food Hydrocoll. 2018, 88, 87–95. [Google Scholar] [CrossRef] [Green Version]
- McKenna, B.A.; Mikkelsen, D.; Wehr, J.B.; Gidley, M.J.; Menzies, N.W. Mechanical and structural properties of native and alkali-treated bacterial cellulose produced by Gluconacetobacter xylinus strain ATCC 53524. Cellulose 2009, 16, 1047–1055. [Google Scholar] [CrossRef]
- Cielecka, I.; Ryngajłło, M.; Bielecki, S. BNC Biosynthesis with increased productivity in a newly designed surface air-flow bioreactor. Appl. Sci. 2020, 10, 3850. [Google Scholar] [CrossRef]
- Krystynowicz, A.; Czaja, W.; Wiktorowska-Jezierska, A.; Gonçalves-Miśkiewicz, M.; Turkiewicz, M.; Bielecki, S. Factors affecting the yield and properties of bacterial cellulose. J. Ind. Microbiol. Biotechnol. 2002, 29, 189–195. [Google Scholar] [CrossRef]
- Kruer-Zerhusen, N.; Cantero-Tubilla, B.; Wilson, D.B. Characterization of cellulose crystallinity after enzymatic treatment using Fourier transform infrared spectroscopy (FTIR). Cellulose 2018, 25, 37–48. [Google Scholar] [CrossRef]
- Czaja, W.; Romanovicz, D.; Brown, R. Structural investigations of microbial cellulose produced in stationary and agitated culture. Cellulose 2004, 11, 403–411. [Google Scholar] [CrossRef]
- Manoukian, O.S.; Sardashti, N.; Stedman, T.; Gailiunas, K.; Ojha, A.; Penalosa, A.; Mancuso, C.; Hobert, M.; Kumbar, S.G. Biomaterials for Tissue Engineering and Regenerative Medicine. In Encyclopedia of Biomedical Engineering; Elsevier: Amsterdam, The Netherlands, 2019; pp. 462–482. [Google Scholar]
- Lin, W.C.; Lien, C.C.; Yeh, H.J.; Yu, C.M.; Hsu, S.H. Bacterial cellulose and bacterial cellulose–chitosan membranes for wound dressing applications. Carbohydr. Polym. 2013, 94, 603–611. [Google Scholar] [CrossRef]
- Zhijiang, C.; Guang, Y. Bacterial cellulose/collagen composite: Characterization and first evaluation of cytocompatibility. J. Appl. Polym. Sci. 2011, 120, 2938–2944. [Google Scholar] [CrossRef]
- Sulaeva, I.; Henniges, U.; Rosenau, T.; Potthast, A. Bacterial cellulose as a material for wound treatment: Properties and modifications. A review. Biotechnol. Adv. 2015, 33, 1547–1571. [Google Scholar] [CrossRef]

| Inoculum Parameters | Enzymatic Digestion BC from Stationary Culture | Enzymatic Digestion BC from Agitated Culture | RMF-Assisted EL-ALB Culture | EL-ALB Culture |
|---|---|---|---|---|
| Log10 CFU mL−1 | 5.18 ± 0.76 a | 6.76 ± 1.14 b | 10.41 ± 1.56 c | 7.72 ± 1.25 b |
| Time (d) | 7 | 4 | 2 | 2 |
| Cycle I | Cycle II | Cycle III | ||
|---|---|---|---|---|
| Total number of cells (log10 CFU mL−1) | RMF-assisted EL-ALB | 10.41 ± 1.56 a | 10.1 ± 1.88 a | 10.07 ± 2.13 a |
| EL-ALB | 7.72 ± 1.25 b | - | - | |
| Mutants (log10 CFU mL−1) | RMF-assisted EL-ALB | 4.12 ± 0.57 a | 4.20 ± 0.42 a | 4.15 ± 0.53 a |
| EL-ALB | 2.24 ± 0.55 b | - | - | |
| Mutants (% of control) | RMF-assisted EL-ALB | 0.00012 a | 0.00013 a | 0.00011 a |
| Properties | Cycle I | Cycle II | Cycle III |
|---|---|---|---|
| SR | 311 ± 27 | 308 ± 31 | 314 ± 42 |
| WHC | 4.41 ± 1.13 | 4.33 ± 0.98 | 4.39 ± 0.59 |
| TS | 2.68 ± 0.10 | 2.35 ± 0.16 | 2.19 ± 0.21 |
| YM | 11.32 ± 1.33 | 12.09 ± 1.98 | 11.85 ± 2.13 |
| EB | 20.54 ± 2.67 | 21.55 ± 3.11 | 21.03 ± 2.87 |
| FD | 55.75 ± 5.56 | 51.83 ± 4.89 | 53.94 ± 4.11 |
| TCI | 1.62 ± 0.13 | 1.57 ± 0.33 | 1.64 ± 0.21 |
Publisher’s Note: MDPI stays neutral with regard to jurisdictional claims in published maps and institutional affiliations. |
© 2021 by the authors. Licensee MDPI, Basel, Switzerland. This article is an open access article distributed under the terms and conditions of the Creative Commons Attribution (CC BY) license (https://creativecommons.org/licenses/by/4.0/).
Share and Cite
Żywicka, A.; Ciecholewska-Juśko, D.; Drozd, R.; Rakoczy, R.; Konopacki, M.; Kordas, M.; Junka, A.; Migdał, P.; Fijałkowski, K. Preparation of Komagataeibacter xylinus Inoculum for Bacterial Cellulose Biosynthesis Using Magnetically Assisted External-Loop Airlift Bioreactor. Polymers 2021, 13, 3950. https://doi.org/10.3390/polym13223950
Żywicka A, Ciecholewska-Juśko D, Drozd R, Rakoczy R, Konopacki M, Kordas M, Junka A, Migdał P, Fijałkowski K. Preparation of Komagataeibacter xylinus Inoculum for Bacterial Cellulose Biosynthesis Using Magnetically Assisted External-Loop Airlift Bioreactor. Polymers. 2021; 13(22):3950. https://doi.org/10.3390/polym13223950
Chicago/Turabian StyleŻywicka, Anna, Daria Ciecholewska-Juśko, Radosław Drozd, Rafał Rakoczy, Maciej Konopacki, Marian Kordas, Adam Junka, Paweł Migdał, and Karol Fijałkowski. 2021. "Preparation of Komagataeibacter xylinus Inoculum for Bacterial Cellulose Biosynthesis Using Magnetically Assisted External-Loop Airlift Bioreactor" Polymers 13, no. 22: 3950. https://doi.org/10.3390/polym13223950
APA StyleŻywicka, A., Ciecholewska-Juśko, D., Drozd, R., Rakoczy, R., Konopacki, M., Kordas, M., Junka, A., Migdał, P., & Fijałkowski, K. (2021). Preparation of Komagataeibacter xylinus Inoculum for Bacterial Cellulose Biosynthesis Using Magnetically Assisted External-Loop Airlift Bioreactor. Polymers, 13(22), 3950. https://doi.org/10.3390/polym13223950











